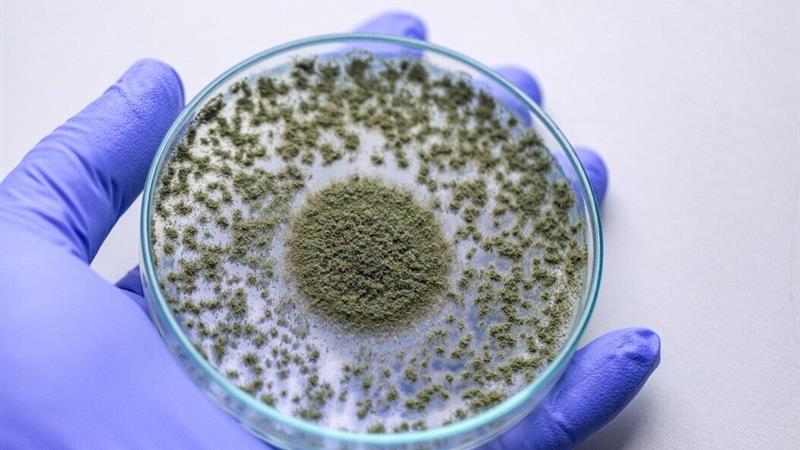
خودکفایی در تولید افزودنیهای خوراکی؛ توکسینبایندر ایرانی سلامت دام را تضمین میکند

خودکفایی در تولید افزودنیهای خوراکی؛ توکسینبایندر ایرانی سلامت دام را تضمین میکند
ایرنا/ کرج - ایرنا- رییس مؤسسه تحقیقات علوم دامی کشور، از تولید و تجاریسازی نسل جدید توکسینبایندر چندجزیی ایرانی با هدف افزایش سلامت تغذیه دام، طیور و آبزیان خبر داد.
"حسن خمیسآبادی" روز یکشنبه درگفت وگو باخبرنگار ایرنا با اشاره به اهمیت این دستاورد گفت: مایکوتوکسینها از جمله آفلاتوکسین B۱، از مهمترین عوامل تهدیدکننده سلامت انسان و دام هستند که در خوراکهای آلوده سبب افت عملکرد و آسیب جدی به سیستم ایمنی و تولید محصولات دامی میشوند.
وی اضافه کرد: برای مقابله با این سموم، استفاده از توکسینبایندرها ضروری است اما تاکنون عمده محصولات مورد استفاده در کشور وارداتی بودهاند و این موضوع وابستگی زیادی ایجاد کرده بود.
خمیسآبادی افزود: با تلاش پژوهشگران مؤسسه و همکاری شرکت دانشبنیان سروش سبز البرز، دانش فنی و فناوری تولید توکسینبایندر چندجزیی داخلی با فرمول اختصاصی شامل آلومینوسیلیکاتها، دیواره مخمر، باکتریهای پروبیوتیکی بومی، بتایین، زغال فعال و ترکیبات گیاهی مؤثره به دست آمد. این محصول علاوه بر دارا بودن فرمول منحصربهفرد، از نظر قیمت و کیفیت رقابتی است و بیش از ۹۵ درصد مواد اولیه آن در داخل کشور تأمین میشود.
رییس مؤسسه تحقیقات علوم دامی کشور یادآورشد : این محصول با نام نویتوکسبایندر اکنون وارد مرحله تولید تجاری شده و در مزارع دام و طیور کشور مورد استفاده قرار گرفته است و آزمایشها نشان دادهاست که این توکسینبایندر توانایی بالایی در جذب انواع سموم قارچی موجود در خوراک دارد و بسته به سطح آلودگی، میزان مصرف آن بین یک تا سه کیلوگرم در هر تن خوراک تعیین میشود.
خمیسآبادی در تشریح آثار اقتصادی این دستاورد گفت: استفاده از نویتوکسبایندر هزینه خوراک مصرفی را بین ۱۱هزارو ۲۳۰ تا ۱۶هزارو ۳۷۰ ریال به ازای هر کیلوگرم وزن زنده کاهش میدهد؛ در حالی که استفاده از نمونه خارجی تنها سه هزارو ۱۸۰ ریال صرفهجویی دارد که در یک سالن ۱۰ هزار قطعهای، این تفاوت معادل حدود ۷۰میلیون ریال صرفهجویی برای پرورشدهنده است و ضریب تبدیل غذایی نیز بهبود محسوسی نشان میدهد.
وی تأکید کرد: این دستاورد گامی مؤثر در جهت خودکفایی، کاهش وابستگی به واردات و ارتقای سلامت محصولات دامی کشور است و نشان میدهد که پژوهشهای ملی میتواند به توسعه پایدار و اقتصاد دانشبنیان در بخش کشاورزی منجر شود.
















